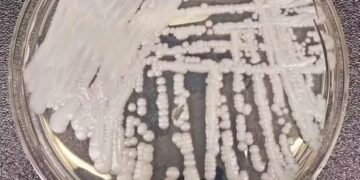

Na manha desta segunda-feira (21), a Banda de Música da Polícia Militar do RN realizou uma apresentação musical de encerramento das atividades do projeto “Música aos Corações” do ano de 2020, no Hospital Central Coronel Pedro Germano – HCCPG (Hospital da Polícia Militar).
A apresentação contou com a participação especial do Capitão PM Moisés, “O policial cantor”. Além do Subtenente Nicodemos (tecladista), Cabo Claudionor (clarinetista), do Cabo Ribeiro (violonista), dentre outros militares que compõem a equipe do projeto. O evento contou ainda com a presença do maestro Capitão PM Mota.
O projeto “Música aos Corações” existe há 11 anos e hoje beneficia quatro instituições, são elas: o Lar da Vovozinha, o HCCPG (Hospital Central Coronel Pedro Germano), o CIADE (Centro Integrado de Assistência Social da IEADERN), e, desde o dia 27 de outubro de 2017, o Hospital Varela Santiago.